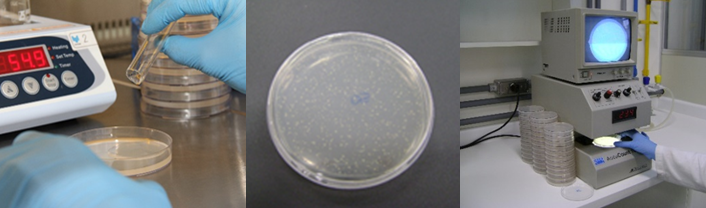

O Setor realiza ensaios de laboratório e estudos sobre os efeitos de contaminantes químicos ambientais na saúde humana e nos ecossistemas. As atividades de laboratório compreendem ensaios de genotoxicidade e ensaios para determinação de cianotoxinas em amostras ambientais. Os ensaios são acreditados pela CGCRE/INMETRO conforme a norma ABNT NBR ISO/IEC 17025. Os resultados servem de subsídio para ações de fiscalização e controle da CETESB. O Setor desenvolve também estudos de toxicologia para avaliar os efeitos de contaminantes químicos ambientais na saúde humana e animal. Elabora pareceres, informações técnicas e fichas de informação toxicológica sobre a presença desses contaminantes e suas consequências para o ambiente e a saúde humana.
A equipe do Setor é multidisciplinar, formada por biólogos, biomédicos e farmacêuticos-bioquímicos, com especialização e pós-graduação.

Ensaios de Genotoxicidade
Os ensaios de genotoxicidade são utilizados para detectar a presença de substâncias genotóxicas em amostras ambientais. Os compostos genotóxicos são aqueles que reagem com a molécula do DNA, produzindo alterações que, se perpetuadas nas células filhas, são denominadas mutações. As mutações gênicas são causa de algumas doenças genéticas e existem evidências substanciais de que as mutações pontuais estão envolvidas na formação de tumores em seres humanos e em animais de experimentação. A presença de compostos genotóxicos em matrizes ambientais tem sido preocupação dos órgãos de meio ambiente no mundo inteiro. Nosso objetivo é verificar a presença de contaminantes que podem alterar o material genético dos organismos, sejam eles da flora e fauna do local estudado ou outros que possam estar expostos a estes compostos
Teste de Salmonella/microssoma (Teste de Ames)
O teste de Salmonella/microssoma foi desenvolvido para detecção de mutagênese induzida quimicamente e é realizado tanto em amostras líquidas quanto em extratos orgânicos. O laboratório avalia amostras de águas, efluentes, solos, sedimentos, lodos e material particulado. O ensaio utiliza diversas linhagens de Salmonella Typhimurium, modificadas geneticamente, na presença e na ausência de ativação metabólica, capazes de detectar compostos que alteram o DNA causando mutações de ponto.

Ensaio do Micronúcleo
O ensaio do micronúcleo permite detectar danos cromossômicos. O laboratório avalia amostras de água superficial e material particulado de ar. O ensaio é realizado in vitro, em culturas de células de mamíferos. O potencial genotóxico da amostra é indicado por um aumento na frequência de micronúcleos na cultura de células expostas.
Determinação de Cianotoxinas

As cianotoxinas são toxinas produzidas por alguns gêneros de cianobactérias, microrganismos que podem proliferar de forma significativa nos corpos d’água em função das atividades humanas e quantidade de nutrientes na água. Algumas cianotoxinas são neurotoxinas potentes e outras podem causar danos ao fígado, rim ou outros órgãos quando ingeridas. As concentrações de cianotoxinas são tipicamente maiores quando ocorrem as chamadas “florações” (espessas camadas de células nas superfícies dos corpos d’água). Porém, nem todas as florações de cianobactérias contêm toxinas e a quantidade de toxina por unidade de biomassa
varia muito. Assim, a fim de garantir a segurança das fontes de água para consumo e recreação, são necessários testes para determinação da concentração dessas toxinas, principalmente em locais com grande densidade de células de gêneros potencialmente tóxicos. O Setor analisa as concentrações de microcistinas, saxitoxinas e cilindrospermopsinas pelo método ELISA (do inglês “Enzyme Linked Immunosorbent Assay”).


FIT – Ficha de Informação Toxicológica
O Setor mantém uma base de dados revisada periodicamente no site da CETESB com informações resumidas de usos e ocorrência de substâncias químicas no ambiente, comportamento nos meios (água, ar e solo), toxicidade e legislação pertinente.
https://cetesb.sp.gov.br/laboratorios/servicos/informacoes-toxicologicas
Cursos e Treinamentos
O Setor ministra cursos e treinamentos práticos especializados com a finalidade de promover a transferência de conhecimentos técnicos e metodológicos na sua área de atuação